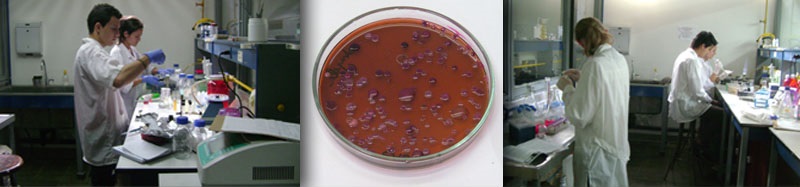

Laboratorio de Microbiología Ambiental y Biotecnología
Presentación
Laboratorio dedicado a investigar sobre los problemas centrales de la Biotecnología ambiental y proponer nuevas metodologías de análisis microbiológico y ecológico para la obtención de consorcios eficientes en la transformación y valorización de contaminantes.
Pruebas que se realizan
En los aspectos de Microbiología Ambiental este laboratorio proporciona servicios a la comunidad en temas como:
Análisis de la flora microbiana en el suelo
- Bacterias:
- Nitrificantes
- Denitrificantes
- Fijadoras de Nitrógeno
- Solubilizadoras de fosfato
- Heterótrofas totales
- Coliformes Totales y Fecales
- Pseudomonas sp
- Hongos:
- Recuento total de hongos y levaduras
- Fitopatógenos
- Actinomicetos
- Métodos moleculares (Fish)
Análisis de flora microbiana en el agua
- Bacterias:
- Heterótrofas totales
- Coliformes Totales y Fecales
- Pseudomonas aeruginosa
- Pseudomonas faecalis
- Bacteriófagos
- Hongos:
- Recuento total de hongos y levaduras
Calidad sanitaria de productos de tratamiento
- Agua potable:
- Recuento de Bacterias heterótrofas
- Recuento de Coliformes totales y fecales
- Recuento de Hongos y levaduras
- Recuento de Pseudomonas aeruginosa
- Recuento de Streptococcus faecalis
- Agua residual:
- Recuento de Bacterias heterótrofas
- Recuento de Coliformes totales y fecales
- Pseudomonas sp
- Compost:
- Recuento de Bacterias heterótrofas
- Actinomicetos
- Presencia/Ausencia de Salmonella sp
- Recuento de Coliformes totales y fecales
- Recuento de Bacterias Fijadoras de nitrógeno
Análisis de sistemas de tratamiento y Lodos
- Producción de Metano: Actividad metanogénica especifica.
- Recuento de Bacterias anaerobias.
- Recuento de sulfooxidantes.
- Recuento de Nitrificantes.
- Recuento de Bacterias Fijadoras de Nitrógeno.
- Recuento de Bacterias Solubilizadoras de fosfato.
- Recuento de Heterótrofos.
- Actinomicetos.
Análisis de Calidad Sanitaria de aguas y alimentos
- Recuento de Mesófilas totales.
- Recuento de Coliformes totales y Fecales
- Recuento de Huevos de Helmintos
- Recuento de Hongos
Asesorías
Para el análisis microbiológicos se utilizan métodos normalizados de la AWWA, WEF, APHA (Standard Methods for examination of water and waste water), 21th edición de Estados Unidos, APHA, AOAC, adaptados a condiciones locales. De la misma forma se utilizan metodologías adaptadas y validadas en el laboratorio.
Coordinadora
Janeth Sanabria Gómez
E-mail: Esta dirección de correo electrónico está siendo protegida contra los robots de spam. Necesita tener JavaScript habilitado para poder verlo.
Contacto
Teléfonos:(57) (2) 321 21 00, Ext. 2412
E-mail: Esta dirección de correo electrónico está siendo protegida contra los robots de spam. Necesita tener JavaScript habilitado para poder verlo.
Página web: http://microbiota.univalle.edu.co/
Ubicación
Universidad del Valle
Facultad de Ingeniería
Escuela De Ingeniería De Recursos Naturales Y Del Ambiente - EIDENAR
Edificio: 336, Espacio: 2002